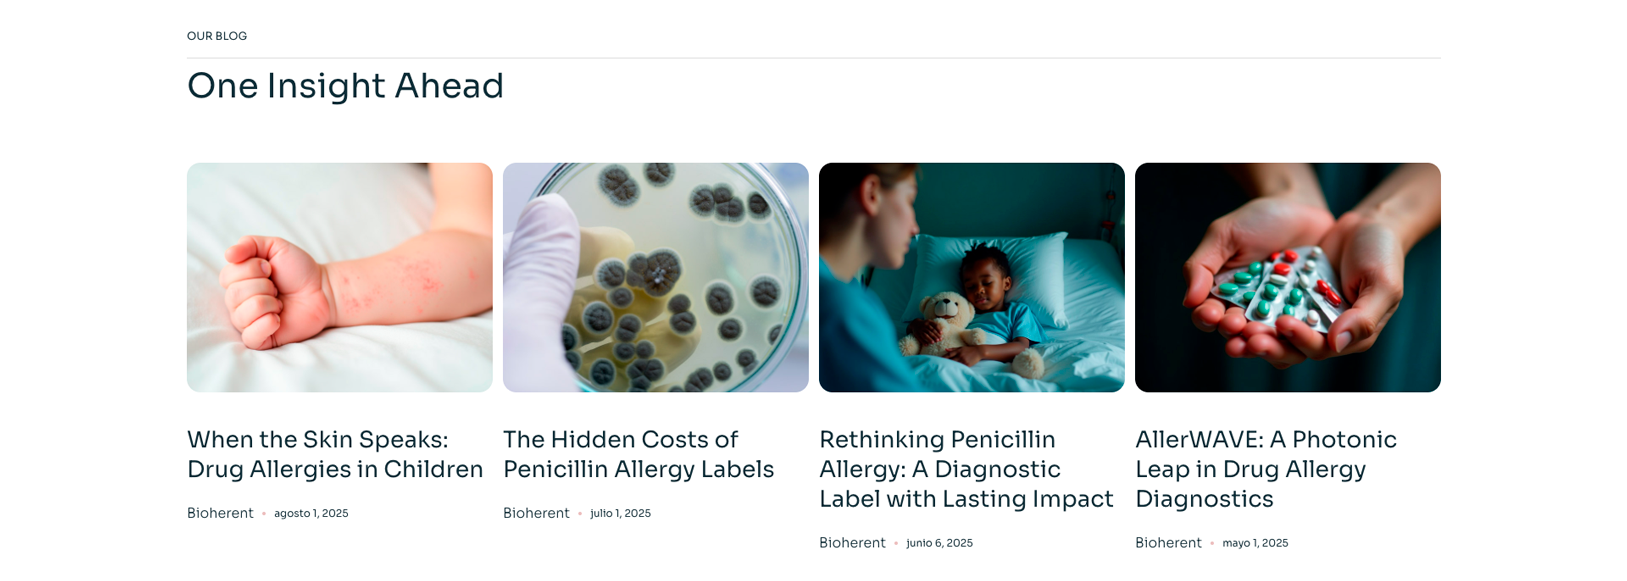

Sector: Biotechnology / Deep Tech
Mercado: Internacional
Servicios: Branding, Web, SEO
Objetivo: Posicionamiento Global
Cómo convertimos la tecnología de Bioherent en una marca capaz de competir a nivel internacional
Bioherent acudió a Brandesign con la necesidad de redefinir su marca y su presencia digital para posicionarse de forma clara y competitiva en el sector biotecnológico. Especializada en el desarrollo de biosensores fotónicos para el diagnóstico clínico de alergias a medicamentos, su tecnología permitía analizar múltiples señales con gran precisión, pero su valor no se estaba comunicando de forma efectiva.
Internamente, la propuesta era clara. Pero externamente, el exceso de información técnica dificultaba su comprensión desde el primer contacto. El mensaje no era inmediato ni accesible, generando una barrera crítica: si el usuario no entiende qué haces en segundos, no llega a percibir tu valor. Como consecuencia, las explicaciones se alargaban y el interlocutor se desconectaba antes de comprender el impacto real de la tecnología.
El reto no era estético, sino estratégico. Había que transformar una tecnología compleja en un mensaje claro, directo y comprensible desde el inicio. Construir una marca capaz de explicar qué hace, para quién y por qué es relevante sin fricción, entendiendo que en este tipo de compañías la claridad no es un extra, sino una ventaja competitiva.

UN NUEVO RETO:
El reto del logotipo de Bioherent no era menor: debía traducir una tecnología compleja basada en coherent detection, representar el universo de la fotónica y la biotecnología aplicada a la salud, y hacerlo además con una estética profesional, tecnológica y futurista. Es decir, no se trataba de diseñar un símbolo atractivo, sino de transformar una lógica científica invisible en una percepción clara y confiable.
El problema del logotipo original es que intenta resolver demasiadas cosas a la vez. Las órbitas exteriores evocan un imaginario cercano a la física o al átomo, mientras que el núcleo verde remite a una estructura molecular o biológica. La combinación pretende sugerir innovación científica, pero no construye una idea visual única. En lugar de transmitir precisión, genera ruido. En lugar de posicionar, obliga al espectador a interpretar.
Ahí está su principal debilidad: funciona más como un diagrama explicativo que como una marca. Se percibe complejo, pero no necesariamente controlado. Y en un sector como el biotech, donde la confianza y la claridad son decisivas, esa ambigüedad resta fuerza.
El anterior logotipo de Bioherent

NUEVA IDENTIDAD VISUAL:
Problema: Una Marca GENÉRICA
El verdadero desafío del briefing no consistía en ilustrar literalmente la tecnología, sino en sintetizar sus cualidades esenciales: coherencia, estructura, señal y precisión. Sin embargo, el contexto inicial condicionaba fuertemente el enfoque. El cliente, con perfil de ingeniero, mostraba especial entusiasmo por las figuras de Möbius como representación de continuidad, así como por los principios de coherent detection, donde tres señales desfasadas 120° reconstruyen una señal en el plano complejo generando estructuras como el círculo y el triángulo isósceles. Esta base científica, aunque sólida y diferenciadora, se trasladó de forma demasiado literal al logotipo. El resultado fue una identidad que, pese a partir de una intención correcta —conectar con la tecnología real—, no filtra ni jerarquiza la información, acumulando códigos visuales y perdiendo claridad. En un entorno competitivo frente a compañías como Siphox, Surfix o Genalyte, y dirigido a hospitales, centros de diagnóstico y laboratorios, esta falta de síntesis derivaba en una marca genérica, poco diferenciada y difícil de interpretar en contextos reales de negocio.
El nuevo logotipo de Bioherent
La nueva identidad visual:
Este logotipo resuelve algo que el anterior no conseguía: sintetizar en una única forma una idea compleja sin necesidad de explicarla. La primera lectura es inmediata y funcional, porque se percibe claramente una “B”, conectando de forma directa con el naming Bioherent. Pero lo relevante no es esa obviedad, sino que la forma no se agota ahí. Al observarla con más detenimiento, aparece una segunda capa conceptual: la referencia a la cinta de Möbius, que introduce la idea de continuidad, flujo y sistema cerrado, alineándose con el pensamiento ingenieril del cliente y con la naturaleza de una tecnología basada en señales coherentes.

Traducir ciencia en una identidad que transmite sin explicar
La base científica, construida sobre la interacción de señales desfasadas que generan estructuras geométricas precisas, nos permitió definir un sistema visual que no era decorativo, sino coherente con su funcionamiento. El símbolo no se diseñó para representar la empresa de forma abstracta, sino para reflejar la idea de precisión, intersección y reconstrucción que define su tecnología.
Este enfoque cambia completamente la percepción.
La marca deja de ser un elemento superficial y pasa a convertirse en una extensión de la propia solución tecnológica. Cuando alguien la ve, no solo percibe una empresa innovadora; percibe estructura, control y fiabilidad.
Y en un sector donde la confianza es imprescindible, esa percepción es lo que abre la puerta a cualquier conversación comercial.

Manual de Identidad Corporativa:
Convertir una marca en un sistema que escala
Una identidad visual, por sí sola, no resuelve nada si no se puede aplicar de forma consistente. Y en el caso de Bioherent, esto era especialmente crítico.
La marca tenía que funcionar en contextos muy distintos: presentaciones a inversores, documentación técnica, comunicación institucional y entornos científicos donde cualquier exceso visual podía jugar en contra. Sin un sistema claro, cada aplicación se convertía en una interpretación, y cada interpretación generaba ruido.
Por eso el siguiente paso fue construir un manual de identidad que no se limitara a definir normas gráficas, sino que estableciera un marco de comportamiento.
Se trataba de definir cómo debía actuar la marca, no solo cómo debía verse.
Este sistema permitió eliminar la dependencia constante del diseñador y dio al equipo de Bioherent una herramienta real para mantener coherencia en todos sus puntos de contacto. Cada decisión visual dejó de ser arbitraria y pasó a responder a una lógica común.
Cuando esto ocurre, la marca deja de ser frágil y empieza a escalar.
Diseño de plantilla corporativa para presentaciones
En el caso de Bioherent, la presentación no se concibe como un soporte visual, sino como una herramienta clave para explicar una tecnología compleja. El diseño de la plantilla se centró en estructurar el discurso y facilitar la comprensión, priorizando una jerarquía clara donde los titulares destacan y el contenido se organiza de forma lógica.
El lenguaje visual mantiene coherencia con la marca: fondos limpios, uso controlado del color y elementos gráficos sutiles inspirados en la fotónica, acompañados de una tipografía sólida que transmite precisión y profesionalidad.
El resultado es una plantilla flexible, pensada para distintos contextos —desde pitch decís, elevados pitch, dossieres que permite comunicar con claridad y reducir la fricción en la transmisión del mensaje.
Estrategia web y SEO
De Landing a web representativa
La web de Bioherent representaba perfectamente el problema inicial: era correcta, pero no cumplía su función.
No estaba pensada para captar, ni para posicionar, ni para explicar de forma eficaz. Era un reflejo de la empresa, pero no una herramienta para hacerla crecer.
El trabajo comenzó entendiendo cómo se comporta el usuario en este tipo de entornos. Qué busca, cómo formula sus consultas, qué necesita validar antes de confiar. A partir de ahí, se definió una estrategia de contenido basada en intención de búsqueda real, no en suposiciones.
Enfoque estratégico y usabilidad
Abordamos cada proyecto web de forma estratégica, donde la información y la experiencia de usuario son el punto de partida. Analizamos qué necesita entender el usuario en cada momento y cómo reducir la fricción en su navegación. El objetivo es construir una arquitectura clara, intuitiva y orientada a la toma de decisiones, donde cada elemento cumple una función dentro del recorrido del usuario.
Estrategia de contenidos
Paralelamente, desarrollamos una estrategia de contenidos alineada con el negocio y el sector. No se trata solo de redactar textos, sino de estructurar mensajes que conecten con las necesidades reales del usuario. Definimos jerarquías de contenido, tono y narrativa, asegurando que la información se presenta de forma comprensible, relevante y orientada a generar confianza.
Keyword research y SEO
Todo este planteamiento se apoya en un análisis de palabras clave exhaustivo. Identificamos las búsquedas reales del sector, tanto a nivel orgánico como competitivo, para detectar oportunidades y posicionamiento. A partir de este estudio, construimos la web en base a términos que hacen match con la intención de búsqueda del usuario, permitiendo no solo atraer tráfico cualificado, sino convertirlo en oportunidades reales de negocio.

Para el diseño de la web, la decisión no fue poner el foco en la tecnología en sí, sino en lo que realmente aporta: el impacto en la vida de las personas. Bioherent no vende solo biosensores, vende la posibilidad de vivir con mayor tranquilidad al conocer con precisión las alergias a medicamentos.
Por eso, el enfoque visual se aleja del imaginario técnico y se acerca a una sensación más humana. Se optó por una imagen que transmite calma, bienestar y equilibrio, construyendo un entorno casi zen que conecta emocionalmente con el usuario. Esta elección no es casual: en un contexto donde el diagnóstico genera incertidumbre, la marca debía proyectar seguridad y serenidad.
El resultado es una web que equilibra tecnología y emoción. Un lenguaje visual limpio, pausado y controlado, que mantiene el rigor científico pero lo envuelve en una experiencia más cercana, accesible y confiable.

EL RESULTADO:
Bioherent no cambió lo que hacía.
Cambió cómo se entendía.
Y en el momento en que eso ocurre, todo lo demás empieza a moverse: las conversaciones, las oportunidades y la forma en la que el mercado responde.
Porque en el mundo deep tech, la diferencia entre avanzar o quedarse atrás no está solo en la innovación.
Está en la capacidad de hacerla comprensible.





¿TU TECNOLOGÍA ES DIFÍCIL DE ENTENDER?
En sectores como el biotech o el deep tech, no basta con tener una solución innovadora. Si tu web no explica con claridad qué haces, no transmite confianza o no conecta con las necesidades reales del usuario, estás perdiendo oportunidades antes de que empiece la conversación. Porque cuando el mercado no entiende tu valor en segundos, simplemente pasa al siguiente.
Trabajé en P&G construyendo marcas globales con estrategias de branding para mercados regionales según cada consumidor. Complementé mi perfil 360º trabajando en agencias de medios para analizar las campañas después del click.
Siempre he estado con un lápiz en la mano, garabateando ideas para diseñar proyectos profesionales en el entorno de las artes digitales, el diseño gráfico, la animación y el 3D. Me encanta ver como paso a paso mis creaciones cobraran vida.
Versátil, resolutivo y productivo. A lo largo de mi trayectoria como periodista y especialista en marketing digital he realizado reportajes, artículos, entrevistas, publi reportajes creando contenidos para las marcas en redes sociales y portales.
Algunos me llaman diseñador, otros director de arte, incluso mi madre dice que soy artista y la verdad es que solo me gustan las etiquetas para diseñarlas.
Busco dar siempre una respuesta y una solución cada vez que recurren a mí, gestiono el servicio de atención al cliente de Brandesign.











































